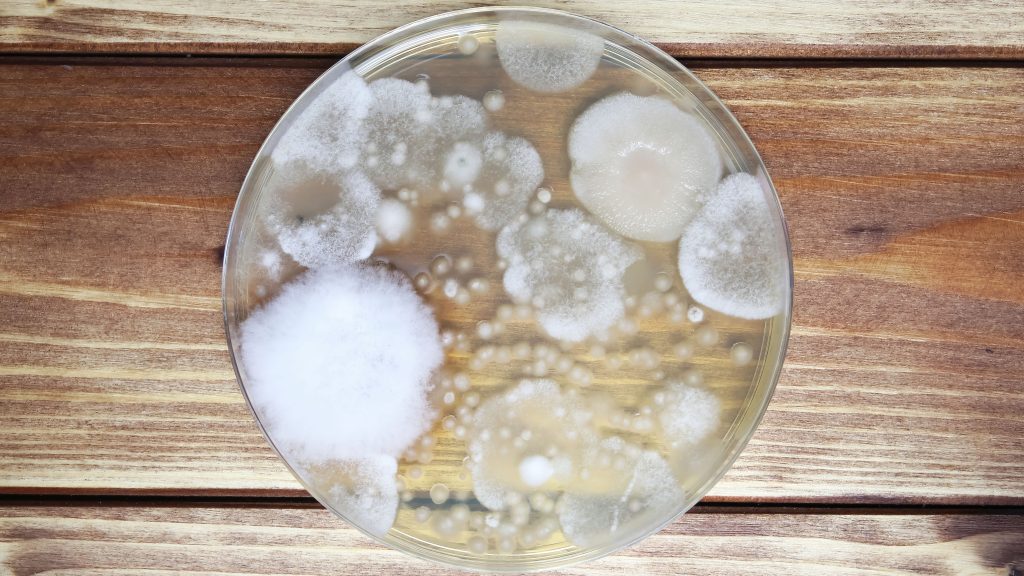

BLACK TRUFFLE PROJECT
An Irish Commercial Winter Black Truffle Orchard
Backed by Biotechnology
Where Nature Meets the Next Era of Innovation
“Own a Truffle Tree. Grow an Asset”
Turn soil, science, and scarcity into long-term value
Become Part of a Pioneering Project
Combining Science, Nature, & Agriculture
Black truffles are one of the most commercially proven luxury crops in Europe — prized for their aroma, culinary demand, and high-value supply chain. Unlike wild harvesting, cultivated orchards can scale production through controlled inoculation, soil preparation, and long-term orchard management. Black Truffle Project brings a modern agricultural venture to the Ireland, merging biotechnology, soil science, and regenerative land use. Alongside premium culinary markets, we also explore the growing opportunity for nutraceutical and cosmetic applications through carefully controlled processing and extraction partnerships.

THE ORCHARD
LAB & INOCULATION

BELOW THE SOIL
Owning a truffle tree isn’t just an investment. It’s a legacy



Why Black Truffles
“Black truffles: commercially proven luxury, with scalable cultivation.”
Winter black truffles (Tuber melanosporum) are one of the most sought-after gourmet ingredients in the world. They are cultivated across parts of France, Spain, and Italy, and traded through established supply chains.
Unlike Italian white truffles, black truffles are more amenable to orchard-based cultivation — making them a strong candidate for stable, long-term production when paired with suitable calcareous soils, host trees, and disciplined orchard management.
Market prices vary by grade and season, but retail benchmarks commonly range in the high hundreds of pounds per kilogram for fresh winter black truffles (with volatility year to year).
Global Market Potential
“What gold is to the earth, truffles are to the soil — a living treasure that renews itself.”
Our Scientific Approach
Seedling inoculation — Oak and hazel seedlings colonized in controlled laboratory settings (T. melanosporum).
Verification — Root-tip colonisation is verified (microscopy and/or molecular checks, as used in your SOP).
Each tree is tagged and mapped. Orchard operations are managed by Lalbenque Farms (or your designated operator), with investors retaining ownership of their trees and receiving annual income once fruiting begins (typically from year 4–6 depending on site conditions and management).
Where Nature Thinks.
AI Analytics
Real-time monitoring of soil conditions, moisture, and orchard health signals.
Mapping & Data
GIS mapping, zone-based soil management, and orchard performance tracking.
Bioactive Pathway
A growing dataset of aroma and bioactive compounds to support product development partnerships.
“AI will change the world — but here, it helps the earth itself to grow.”
Why Now
“The world is changing — and not everyone will keep up.”
We believe now is the right time to invest. Automation, AI, and climate change are reshaping the global economy. In uncertain markets, tangible, productive assets tied to land and food systems can offer long-duration value. Black truffles sit at the intersection of luxury demand and biological scarcity — and orchard cultivation enables that scarcity to be addressed with science, management, and time.
- AI and automation are reshaping employment and entire industries.
- Many sectors face disruption and volatility; investors increasingly seek real-asset exposure.
Meanwhile, agriculture and biotechnology remain among the few sectors that are:
- Tangible: rooted in real assets, not digital volatility
- Essential: feeding both people and industries
- Future-proofed: increasingly enhanced, not replaced, by technology
AI Impact on Industries
Investment Overview
A tangible asset — backed by land and long-term orchard economics
Investing in the Black Truffle Project means owning real agricultural assets.
Living truffle trees, each linked to verified shares in Black Truffle Project Ltd.
This is not a fund or digital token — it’s a direct stake in a physical, productive asset.
SEIS/EIS (UK ONLY)
Our company has been approved under the UK Government’s Seed Enterprise Investment Scheme (SEIS) and their Enterprise Investment Scheme (EIS).
This means that qualifying investors can benefit from:
- 30% – 50% Income Tax relief on the amount invested
- No Capital Gains Tax on profits from EIS shares (if held for 3+ years)
- Loss relief if the investment underperforms
- Inheritance Tax exemption after 2 years
SEIS/EIS assurance provides an additional layer of security and legitimacy — your investment is officially recognised and approved by HMRC under the Enterprise Investment Scheme.
SEIS/EIS applies only to share-based investments made via our upfront payment option.

Payment Options
“A future you can literally grow.”
Upfront Investment (SEIS/EIS Eligible)
£699 / Tree
- Full ownership of one truffle tree
- 50/50 yield split with WTP
- investor privileges
- Buy-back guarantee: 10 years
Subscription Plan
£20 / Tree
- Gradual ownership over 3 years
- Yield rights upon completion
- investor privileges from month 1
- Buy-back guarantee: 10 years
Investor
Tree
Shares
Yield
Return
Investor Privileges

10+ Trees = Advisory Board Membership
Advisory Board Access
investors with 10+ trees gain membership and periodic strategy sessions.
Bi-Annual Events
AGM and harvest celebration, orchard visits and networking.
Exclusive Tastings
curated culinary experiences using orchard harvest (where available).
Lab & Innovation Tours
behind-the-scenes access to inoculation and monitoring systems.
Forecasted Revenue & Returns
Projected Revenue on 30 year Model
£616 K
£1.6 M
Total Revenue (30 years)
£3.19 M
30 Year Timeline

Planting & Establishment

First Harvest

Stabilised Yield

Peak Production

Mature Orchard
Revenue Split
£2,200
Real wealth isn't made — it's grown.
Biodiversity Restoration
mycorrhizal networks, soil microbiome diversity.
Carbon Capture
orchards sequester carbon while producing premium goods.
Intergenerational Wealth
long-duration asset value that can be passed on.
Verification — Root-tip colonisation is verified (microscopy and/or molecular checks, as used in your SOP).
Black Truffle Project Ltd — Pioneering the Future of Sustainable Wealth.
Contact
Get in Touch
Legal & Disclaimers
- Black Truffle Project Ltd is a UK registered entity.
- Investments in agricultural and biotech ventures carry the risk of loss of capital.
- Any tax relief scheme eligibility depends on investor status and may change.
- This website does not constitute an offer in regulated jurisdictions. Full terms and conditions apply.
Investing in agricultural biotechnology carries inherent risks. Yields depend on environmental, climatic, and biological factors; truffle prices may fluctuate. While operations may include insurance and professional management, returns are not guaranteed and investors may lose part or all of their capital.

